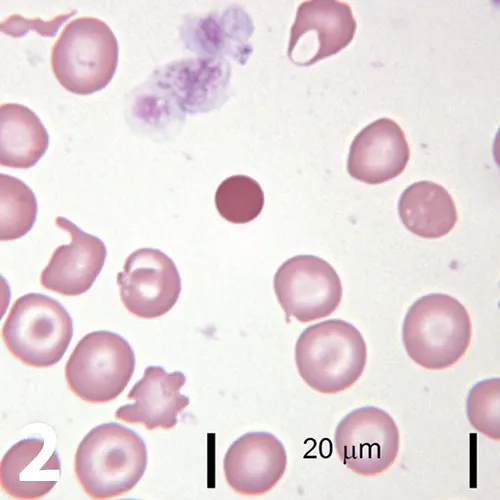
Featured Image
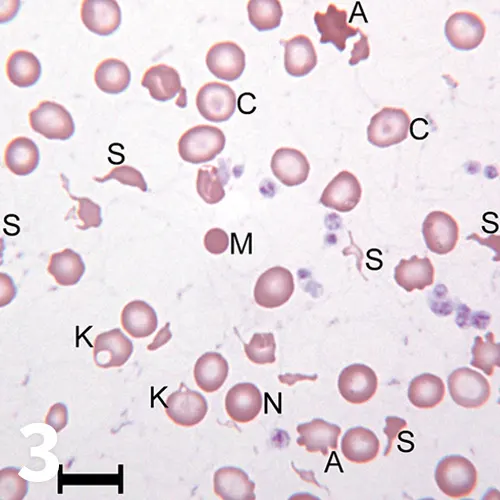
Featured Image
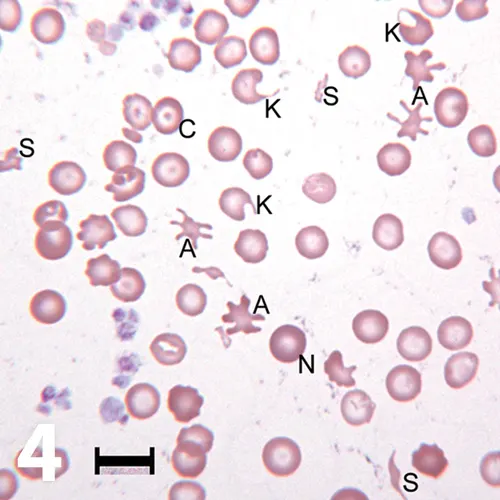
Featured Image

Newfoundland With Dermatologic Disease & Osteoarthritis

A 6-year-old castrated Newfoundland was presented to its regular veterinarian for nonspecific signs of lethargy and inappetence.
History
The patient, which had also exhibited pica, had been receiving long-term methylprednisolone therapy for more than 6 months for dermatologic disease and joint supplements for osteoarthritis. An initial CBC and serum chemistry panel were performed. Based on the results and a blood film evaluation, the patient was referred for further evaluation and treatment of suspected immune-mediated hemolytic anemia.
Related Article: What Type of Anemia?
Physical Examination
Mucous membranes were pale pink, the patient was tachycardic, and there was soft stool without evidence of hemorrhage on rectal examination. Seborrhea and alopecia, consistent with the history of chronic dermatopathy, were also noted.
Figure 1. A 50× objective field of the patient’s blood film is shown with thrombocytosis and several changes in RBC size, shape, and color. (bar = 10 μm, Wright- Giemsa)

Figure 2. A 100× objective field is pictured with findings similar to Figure 1. Several changes in RBC size, shape, and color are present along with an aggregate of large platelets.
Laboratory Evaluation
CBC confirmed anemia (Table 1, Figures 1 and 2). Additional pertinent CBC findings included a mild thrombocytosis of 536 (reference interval 134-396 × 103/μL) and a mild lymphopenia of 0.5 (reference interval 0.9- 3.4× 103/μL). The patient’s creatinine was minimally elevated at 1.5 (reference interval 0.3-1.4 mg/dL), and the blood urea nitrogen (BUN) was within reference interval at 14 (reference interval 7-25 mg/dL). Urinalysis performed later in the hospital stay revealed a specific gravity of 1.030. This indicated adequate concentrating ability: thus, the mild azotemia was believed to be prerenal in origin. Before blood film evaluation, IV dexamethasone was given as therapy for possible immune-mediated hemolytic anemia. The patient’s blood was typed and crossmatched in case the anemia worsened.
ASK YOURSELF
What abnormalities of RBC size, shape, and color are present in the blood film?
What are some differential diagnoses for microcytic, hypochromic anemia?
What is the most likely mechanism for this patient’s anemia given the historical, CBC, and blood film findings?
Hemogram Data
MCHC = mean cell hemoglobin concentration, MCV = mean cell volume, RBC = red blood cell, PCV = packed cell volume, RDW = red blood cell distribution width
*PCV is performed manually using a microhematocrit tube. The hematocrit is a calculated value performed by the hematology analyzer, which provides similar information. The values were in agreement, so only the PCV is listed.
Diagnosis
Iron deficiency anemia caused by chronic blood loss
Interpretation & Discussion
Iron deficiency is indicated by the constellation of these CBC and blood film findings:
Anemia
Microcytosis
Hypochromasia
Codocytes (target cells)
Poikilocytosis consistent with RBC fragmentation (eg, acanthocytes, keratocytes, schistocytes, microspherocytes)
Thrombocytosis
Microcytosis (low MCV) occurs because erythrocyte precursors divide into increasingly smaller RBCs until an ideal concentration of hemoglobin for the cell surface area is reached.1 The large number of microcytic RBCs contributes to increased anisocytosis (increased RDW). Microcytosis typically occurs before hypochromasia (low MCHC). Hypochromic RBCs or hemoglobin-deficient RBCs have increased central pallor with more than one-third of the center of the cell pale.
Hemoglobin-deficient RBCs may also appear as codocytes because such RBCs are thinner than normal because of reduced cytoplasmic hemoglobin. Hemoglobin-deficient RBCs are fragile and prone to intravascular fragmentation, which results in increased numbers of acanthocytes, keratocytes, schistocytes, and microspherocytes. The erythrocyte regenerative response is variable in cases of iron deficiency. The degree of polychromasia and reticulocytosis depends on the magnitude of iron store depletion. In this case, polychromasia was minimal, which is consistent with inadequate body iron to support erythrocyte regeneration. Reactive thrombocytosis frequently accompanies iron deficiency anemia. The mechanism of the thrombocytosis has not been conclusively characterized.
In the preparation, note the thin RBC density, consistent with anemia. Increased numbers of acanthocytes (A), keratocytes (K), schistocytes (S), and codocytes (C) are present. A microspherocyte (M) is also present in Figure 3.
A normocytic and normochromic cell (N) is labeled for comparison to the surrounding microcytic or hypochromic cells. Increased platelets are seen in Figure 4. (50× objective, bar = 10 μm, Wright-Giemsa)
Confirming Diagnosis
Additional diagnostics, including fecal tests and imaging, were performed to determine the cause of the iron deficiency. Fecal flotation and direct wet mount examination were negative for parasites. The presumptive working diagnosis was GI blood loss secondary to corticosteroid administration. GI blood loss, which may be occult as in this case, is a frequent cause of iron deficiency.1 The patient was placed on a proton pump inhibitor and iron supplementation and was slowly weaned off of methylprednisolone. Nephroliths were identified on the abdominal ultrasound but likely did not contribute to occult blood loss in this case because hematuria was not present and the patient responded to supportive care and discontinuation of corticosteroids. The patient’s PCV increased to 27% within 2 weeks of starting iron supplementation and continued to improve under the care of the primary veterinarian. Most iron deficiency anemia cases take months to fully resolve with appropriate treatment.
Related Article: Gastric Ulceration/Erosion
DID YOU ANSWER?
The erythrocyte density is thin, which suggests anemia. Paler-than-normal RBCs with increased central pallor (hypochromasia) and smaller-than-normal RBCs (microcytes) are present. There is also increased variation in RBC size (anisocytosis). Abnormal RBC shapes have formed (poikilocytosis), including keratocytes, schistocytes, acanthocytes, microspherocytes, and codocytes.
Considerations for a microcytic hypochromic anemia include:
Absolute iron deficiency anemia secondary to chronic external or nonresorptive blood loss1-4
Functional iron deficiency anemia of inflammatory disease,2,4 though anemia of inflammatory disease is usually normocytic and normochromic and infrequently hypochromic
Portosystemic shunts,2,4 though many cases are microcytic and normochromic
Malnutrition is possible but rarely contributes to iron deficiency in small animals4
The mechanism for the anemia was most likely chronic external blood loss from the GI tract secondary to prolonged corticosteroid administration. The microcytosis, hypochromasia, poikilocytosis associated with fragmentation, and thrombocytosis were consistent with iron deficiency; however, the patient’s skin condition may have been a contributing factor and caused anemia of chronic inflammation. Given the classic presentation suggestive of iron deficiency, additional diagnostics (eg, serum ferritin) were not pursued.
Related Article: Corticosteroid & Nonsteroidal Antiinflammatory Drug Interactions
Closing Thoughts
This case illustrates the utility of evaluating blood films and RBC indices (eg, MCV, MCHC) for patients with anemia. This information can be rapidly obtained using microscopy and in-house hematology analyzers. These results help clinicians optimize diagnostic and therapeutic plans and avoid pitfalls associated with incorrect treatment and testing.
MCHC = mean cell hemoglobin concentration, MCV = mean cell volume, PCV = packed cell volume
_HEATHER L. WAMSLEY, DVM, PhD, DACVP (Clinical Pathology), is veterinary clinical pathologist at Antech Diagnostics in Tampa, Florida. Since 2004, Dr. Wamsley has instructed urinalysis and other clinical pathology wet labs at the NAVC Conference, in addition to participating in a hematology masterclass and cytology symposium. A graduate of University of Wisconsin–Madison, she earned a doctorate in molecular biology of infectious diseases from University of Florida.
AMY L. WEEDEN, DVM, recently completed her clinical pathology residency at University of Florida. Prior to her residency, Dr. Weeden completed a shelter animal medicine and surgery internship at Colorado State University and was an associate in private small animal practice for 8 years. She is a graduate of Louisiana State University._